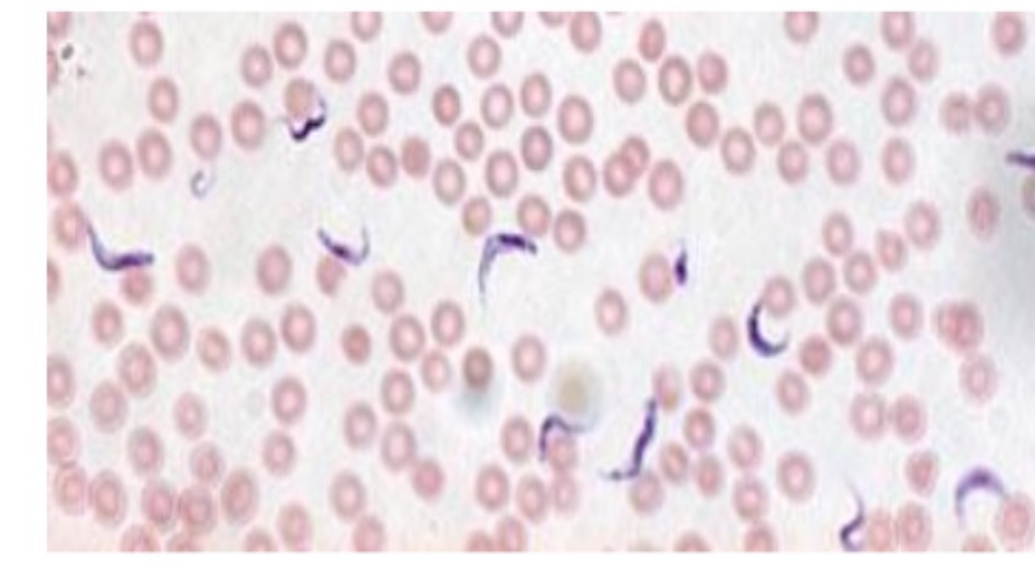

1/18
Looks like no tags are added yet.
Name | Mastery | Learn | Test | Matching | Spaced | Call with Kai |
|---|
No analytics yet
Send a link to your students to track their progress
Chlamydomonas

Spirogyra

Volvox

Diatoms

Desmids

Anaebena

Gleocapsa

Oscillatoria

Spirulina

Paramecium

Blepharisma

Vorticella

Amoeba

Euglena

Stentor

Trypanosoma spp
Plasmodium (ring stage)

Giardia lamblia

Trichomonas vaginalis
